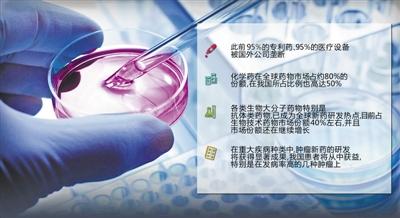
西达本胺GDP_西达本胺

西达本胺GDP_西达本胺
时间:2021-03-31 09:36 类别:热点图片
正因为如此,西达本胺片成了微芯生物最大的收入来源。
其中,西达本胺是目前微芯生物的主要的收入来源,2016年-2018年三年内,西达本胺片的产品销售收入和西达本胺境外专利授权许可收入的合计分别为8529.96万元、1.103亿元和1.465亿元,分别占微芯生物同期营业收入的99.92%、99.81%和99.
据专家介绍,西达本胺对 抗癌新药 丨 西达本胺,作为全球仅有4
由于国内目前还没有竞品上市,预计西达本胺应用于外周t细胞淋巴瘤的潜在市场规模约为6亿元/年。
已经商业化的西达本胺成为了该公司吸金产品, 2016至2018年,上市产品西达本胺为其贡献的销售收入从65.32%增长至92.57%。
业务结构上,目前收入依赖核心产品西达本胺,2018年西达本胺的收入占比达92.58%,公司另有小部分的技术授权许可费收入。
西达本胺
中国自主知识产权的原创抗癌新药西达本胺片)
继西达本胺之后,微芯生物后继还有哪些品种
截至“十二五”末,累计90个品种获得新药证书,其中包括手足口病ev71型疫苗、sabin株脊灰灭活疫苗、西达本胺、阿帕替尼等24个1类新药,是重大新药创制国家科技重大专项实施前总和的5倍。
因此,西达本胺的销售并不火爆。
西达本胺的研发者
在哪里能买到西达本胺,多少钱
西达本胺片2018年重点城市销售额同比
西达本胺联合各方案均显示增效,
那么,对这类患者进行西达本胺治疗,效果会不会改善?
然而令周合冰感到吃惊的是,张宗花在服用西达本胺之后,很快发生了疗效,基本上用了第四个疗程以后就稳定了,到12月份化疗结束。
微芯生物主要的收入来源是其独家产品西达本胺,该药是全球首个亚型选择性组蛋白去乙酰化酶抑制剂
西达本胺是鲁先平带领微芯团队经过12年研发出来的原创新药,主要对抗淋巴瘤,目前,
the lancet oncology在线发表江泽飞教授等中国乳腺癌专家领衔的ace研究结果,原创新药西达本胺再登世界舞台
西达本胺抗肿瘤分子作用机制(来源:微芯生物官网)
推荐阅读
相关文章阅读
- 最新文章
- 总排名
- 每月排行
- 推荐阅读
- 阅读排行
- 延伸阅读